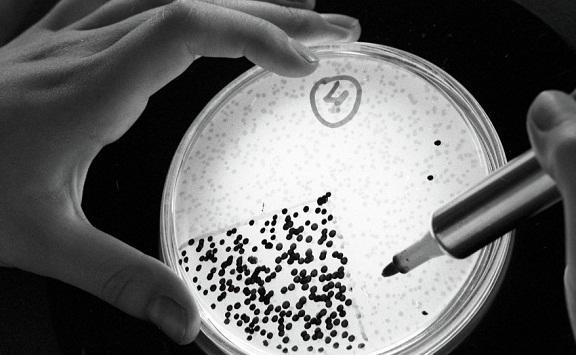
أكثر من 12 مليون وفاة نتيجة عدوى ببكتيريا في 2019

خبرني - أفاد تقرير نشر اليوم الخميس أن أكثر من 1.2 مليون شخص توفوا في عام 2019 بإصابات ناجمة عن بكتيريا مقاومة لمضادات حيوية متعددة، وهو رقم أعلى من رقم الوفيات الناجمة عن الإصابة بفيروس نقص المناعة المكتسب (الإيدز) أو بسبب الملاريا.
وحذر مسؤولو الصحة في العالم مرارا من تزايد البكتيريا والميكروبات الأخرى المقاومة للعقاقير بسبب إساءة استخدام المضادات الحيوية أو الإفراط في تناولها الأمر الذي يشجع الكائنات الحية الدقيقة على التطور إلى "جراثيم خارقة".
وكشف التقرير الجديد عن "البحث العالمي بخصوص مقاومة المضادات الميكروبية"، المنشور في نشرة لانست الطبية، أن المقاومة للمضادات الميكروبية مسؤولة بشكل مباشر عما يقدر بنحو 1.27 مليون وفاة وأنها كانت من بين أسباب الوفاة في نحو 4.95 مليون حالة.
وحللت الدراسة بيانات من نحو 204 دول وأقاليم.
وقال كريس موراي الأستاذ في جامعة واشنطن الذي شارك في إعداد الدراسة "هذه البيانات الجديدة تكشف الحجم الحقيقي لمقاومة المضادات الميكروبية في العالم... كانت تقديرات سابقة توقعت عشرة ملايين وفاة سنويا بسبب مقاومة المضادات الميكروبية بحلول عام 2050، لكننا الآن نعلم عن يقين أننا بالفعل أقرب بكثير مما كنا نعتقد من ذلك الرقم".
وكانت منظمة الصحة العالمية حذرت العام الماضي من أن 43 مضادا حيويا يجري تطويرها أو تمت الموافقة عليها مؤخرا لا تكفي لمحاربة المقاومة للمضادات الميكروبية.
وقال كورنيليوس كلانسي، أستاذ الطب في جامعة بيتسبرج إن إحدى الطرق للتعامل مع مقاومة المضادات الميكروبية هي التطلع إلى أسلوب جديد للعلاج.
ومعظم الوفيات المعنية في عام 2019 نجمت عن التهابات بسبب مقاومة الأدوية في الجزء السفلي من الجهاز التنفسي مثل الالتهاب الرئوي تتبعها التهابات في مجرى الدم والتهابات داخل البطن.
وتأثير مقاومة المضادات الميكروبية أشد الآن في أفريقيا جنوب الصحراء وفي جنوب آسيا، في حين يتركز حوالي خُمس الوفيات في الأطفال دون الخامسة من العمر.
وكان توافر البيانات من بعض المناطق محدودا، وخصوصا في كثير من البلدان محدودة ومتوسطة الدخل مما يحد من دقة تقديرات الدراسة.
قال كلانسي إن التركيز كان على كوفيد-19 في العامين الأخيرين لكن مقاومة المضادات الميكروبية هو من "نوع التحديات طويلة الأجل".